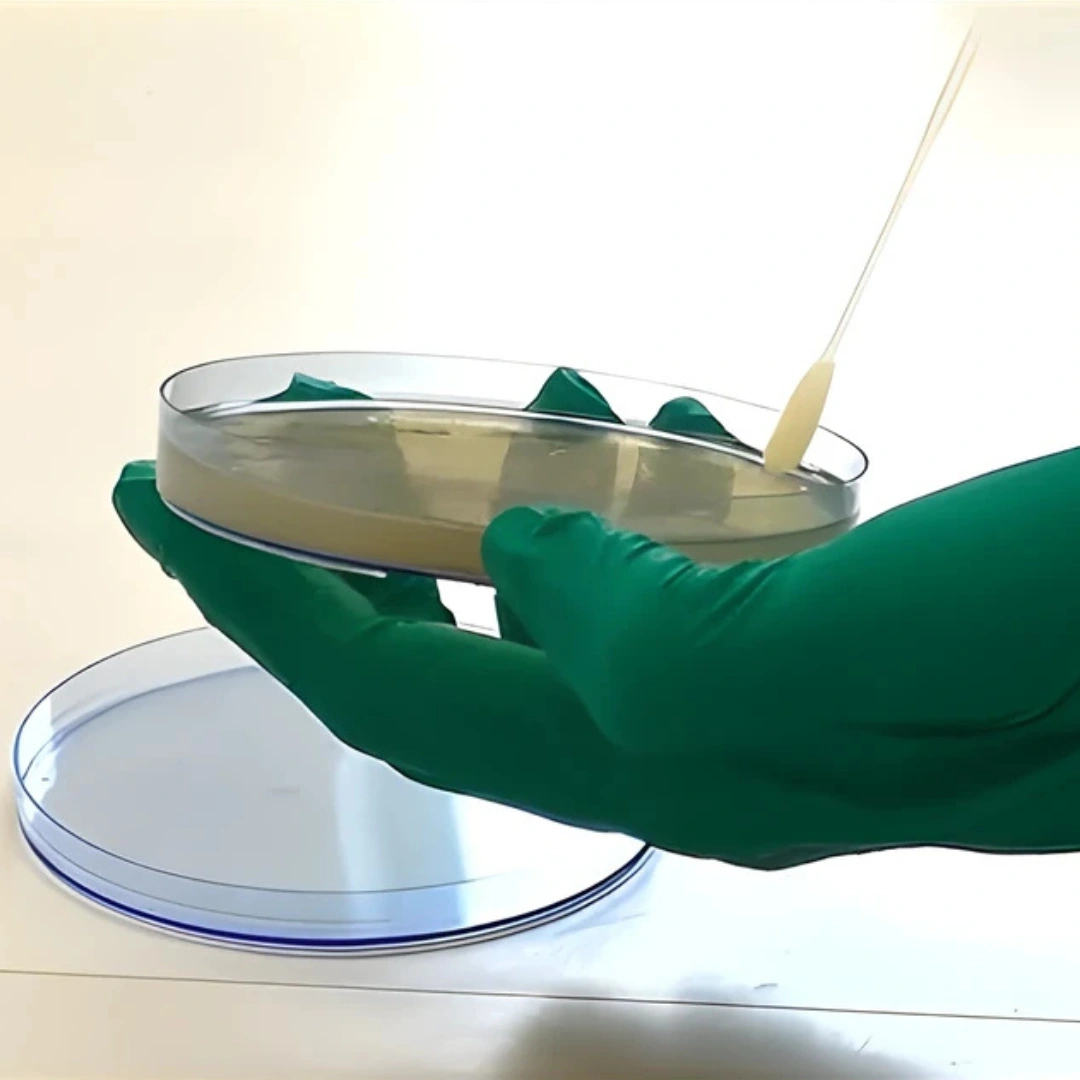
ENVIORMENTAL MONITO- RING - 05 SWABS

Environmental Monitoring – 05 Swabs
What it is
The Environmental Monitoring – 05 Swabs test is a microbiological evaluation that uses five sterile swabs to collect samples from different environmental surfaces. This test helps detect and identify microbial contamination in workplaces where hygiene and contamination control are critical, such as pharmaceutical manufacturing, food processing, biotechnology labs, and healthcare facilities.
Uses
This test is used to monitor surface cleanliness, validate sanitation procedures, and ensure compliance with regulatory standards such as GMP (Good Manufacturing Practices), HACCP (Hazard Analysis and Critical Control Points), or ISO guidelines. Multiple swabs allow sampling of various surfaces or equipment points to provide a broader view of contamination risks in the monitored environment.
When It May Be Recommended
Environmental swab monitoring is recommended during routine quality checks, after cleaning and disinfection procedures, during facility validation, or in response to contamination concerns. It may also be conducted after equipment maintenance or process deviations to verify hygienic conditions.
Abnormal Results
Positive Growth: Indicates the presence of microbial contamination. Depending on the level and type of organism detected, corrective measures may include re-cleaning, adjusting sanitation protocols, or investigating contamination sources.
Negative Growth: Suggests effective cleaning and absence of detectable microbial contamination on the tested surfaces.
Risks
The procedure is non-invasive and safe, involving only environmental surface swabbing. Risks are minimal and limited to potential errors in sampling or handling, which could affect accuracy. There are no health risks to staff or patients.

Reviews
There are no reviews yet.